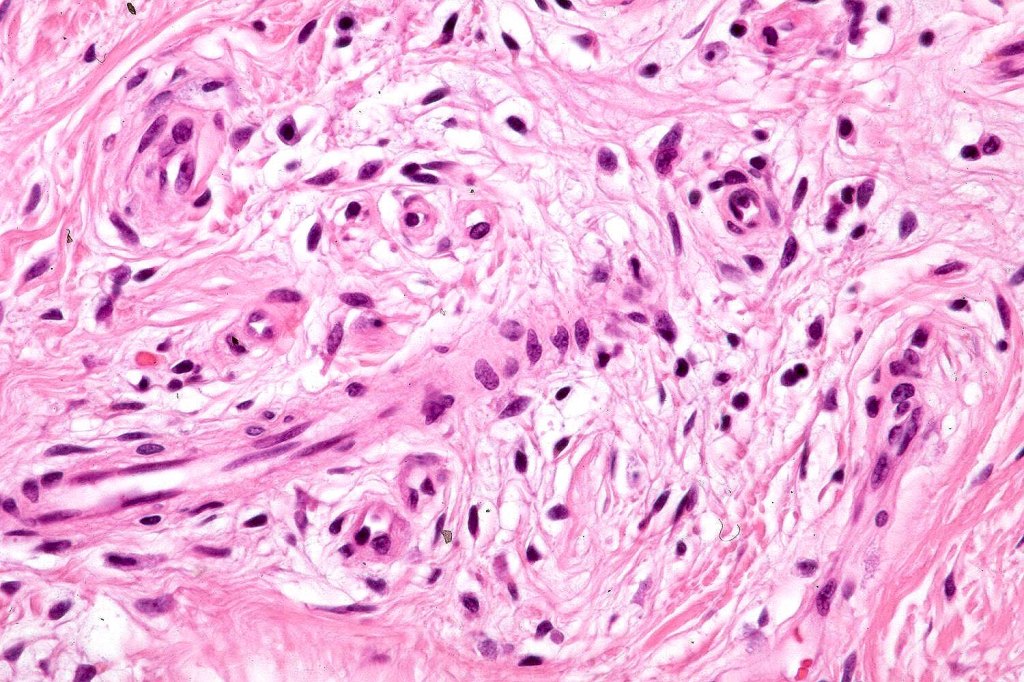

Clinical features
•Rare, generally presenting as a solitary, flesh-colored papule or nodule on the central face with a predilection for the nose
•Often presents in children
•Less commonly affected sites include the scalp, nipples, limbs & external genitalia
•0.5-2.5 cm diameter
•Giant variant
•Non-syndromic
•Not associated with Muir-Torre syndrome
Histological features
•Circumscribed dermal nodule with a characteristic silhouette
•An infundibular cyst is surrounded by laminated dermal collagen, elastic fibers, blood vessels, adipocytes & spindle cells separated from the adjacent dermis by a retraction artifact
•The cyst contains keratinous debris, and its wall shows conspicuous sebaceous & sometimes hair follicular elements are also evident
•Significant association with Miescher nevus (as high as 20% for nasal lesions)
•Exceptionally may show spindle cell lipoma-like features
•Exceptionally includes a neural component
•Some authors believe that this entity overlaps sebaceous trichofolliculoma

Differential diagnosis
Folliculosebaceous cystic hamartoma can be distinguished from trichofolliculoma/sebaceous trichofolliculoma by the striking connective component and retraction artifact.
Leave a comment